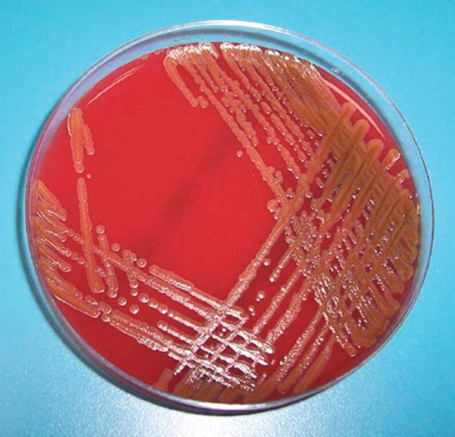

Reporte de caso y revisión de tema
Bacteriemia asociada a catéter tunelizado por Chryseobacterium indologenes, en un paciente de hemodiálisis
Bacteriemia associated with a catheter tunneled by Chryseobacterium indologenes, in a hemodialysis patient
Bacteriemia asociada a catéter tunelizado por Chryseobacterium indologenes, en un paciente de hemodiálisis
Revista Colombiana de Nefrología, vol. 6, núm. 2, pp. 166-171, 2019
Asociación Colombiana de Nefrología e Hipertensión Arterial
Recepción: 11 Diciembre 2018
Aprobación: 23 Abril 2019
Resumen: La bacteriemia asociada a catéter representa una parte importante de la morbilidad en pacientes con terapia de reemplazo renal, el Chryseobacterium indologenes (CI) es una bacteria gram negativa que afecta principalmente a pacientes con estancias hospitalarias prolongadas; la mayoría de casos reportados hasta el momento han ocurrido en Asia. El presente artículo reporta un caso identificado en la ciudad de Cali, Colombia, de un paciente que recibe hemodiálisis con el propósito de establecer los factores de riesgo que tienen los pacientes afectados por C. indologenes y conocer más acerca de las características microbiológicas y el espectro de sensibilidad y resistencia de esta bacteria, con el fin de establecer los protocolos de tratamiento para la bacteriemia asociada a catéter.
Palabras clave: Chryseobacterium, bacteria aeróbica gram negativa, Unidad de hemodiálisis hospitalaria, catéter de permanencia, diálisis, bacteremia.
Abstract: Catheter-associated bacteremia represent an important part of the morbidity in patients with renal replacement therapy, Chryseobacterium indologenes is a gram-negative bacterium that mainly affects patients with prolonged hospitalization; the majority of cases reported until now occurred in Asia. This article presents a case identified in Cali, Colombia, in a patient receiving hemodialysis, with the purpose of establishing the risk factors for the patients affected by C. indologenes, and know more about the microbiological characteristics, the spectrum of sensitivity and resistance of this bacterium, in order to establish treatment protocols for catheter-associated bacteremia.
Key word: Chryseobacterium, gram-Negative aerobic bacteria, hemodialysis units, hospital, catheters, indwelling, dialysis, bacteremia.
Introducción
el control de la bacteriemia/sepsis por catéter es un reto para el personal de salud en un paciente inmunocomprometido1. El panorama se encuentra aún en mayores encrucijadas si se observa las adaptaciones que han desarrollado las bacterias para expresar multirresistencia2. Tabla 1. Teniendo en cuenta la aparición de nuevas especies y su importante impacto clínico; se presenta el caso de un aislamiento de Chryseobacterium indologenes (CI) en un paciente de hemodiálisis, del cual no hay reportes publicados en Colombia, solo hay 24 referencias bibliográficas en el mundo, ninguna de ellas respecto a pacientes en diálisis crónica.

Las especies de Chryseobacterium son un grupo de bacilos gramnegativos que no son móviles; no obstante son catalasa-positivo, oxidasa-positivo, indol positivo y realizan fermentación sin glucosa. El género Chryseobacterium incluye 6 especies que fueron previamente designadas como miembros del género Flavobacterium C. gleum y C. indologenes, anteriormente conocidos como Flavobacterium que corresponden al grupo IIb del CDC, se han diferenciado por ADN-ADN homólogo y ocho características fenotípicas.
Por otra parte, es importante mencionar que el C. meningosepticum y el C. indologenes son dos especies comúnmente aisladas de muestras clínicas, no obstante, el C. meningosepticum es el miembro más patogénico del género. Sin embargo, la importancia clínica del C. indologenes no se ha establecido completamente, dado que esta bacteria no se recupera frecuentemente de muestras clínicas. El C. indologenes es un patógeno raro en seres humanos y normalmente no está presente en la microflora humana, aunque está ampliamente distribuido en la naturaleza. Actualmente sólo hay 42 casos reportados de bacteriemia por C. indologenes en la literatura, con la mayoría de los casos reportados en Taiwán y solo uno está asociado a pacientes en hemodiálisis3.
Presentación del caso
Paciente masculino de 75 años, con antecedente de nefropatía diabética grado 5, quien recibe hemodiálisis durante 2 meses, ingresó con un catéter temporal luego de una estancia hospitalaria prolongada por sepsis de origen urinario. Fue hospitalizado, donde inició su terapia renal crónica, en la nota de egreso se relató exposición a antibióticos carbapenémicos por una infección intrahospitalaria por Acinetobacter baumanii, el paciente ingresó al servicio de hemodiálisis, se cambió a catéter tunelizado sin complicaciones; a las 3 semanas ingresó con fiebre, escalofríos y el catéter expuesto, se tomó cultivo y este fue positivo para S. epidermidis, posteriormente se cambió el catéter y se trató con cefazolina durante 3 semanas, se colocó nuevo catéter tunelizado al finalizar el tratamiento, a las dos semanas el paciente presentó de nuevo escalofrío en casa, se tomaron 2 hemocultivos y cultivo de sangre del catéter, reportados positivos para Chryseobacterium indologenes (CI) (Tabla 2), sensible solo a carbapenémicos y aminoglucósidos, se trató con amikacina y meropenem (figura 1), se cambió de nuevo el catéter, se tomaron cultivos de los puertos de la máquina de hemodiálisis, del agua pos osmosis inversa y de varios puntos del anillo de distribución, siendo todos ellos negativos. Se realizó visita domiciliaria y se evidenció que el paciente habita en una casa de inquilinato, donde comparten los puntos de agua, además el paciente frecuentemente sale a lugares donde hay humedad y tiene un pobre autocuidado.

Microbiología
El Chryseobacterium indologenes es una Chryseobacteria que hace parte del grupo de bacilos aeróbicos gramnegativos, inmóviles, catalasa y oxidasa positivas. El C. meningosepticum es el subtipo más patogénico como se mencionó con anterioridad, mientras, el C. indologenes es el más frecuente aislado, habitualmente en inmunocomprometidos, además el uso previo de antibióticos de amplio espectro y las hospitalizaciones prolongadas son los principales factores de riesgo4.
El Chryseobacteria representa un 0,03% del total de aislados y es culpable del 0,03% de todas las bacteriemias4. Taiwán es el país que más reporta casos en la literatura (al menos 38 aislamientos).
Las infecciones asociadas con mayor frecuencia son: bacteriemia, intraabdominales y de herida operatoria. Por otra parte, las enfermedades oncológicas y la diabetes mellitus son las principales patologías asociadas.
Dicha bacteria la podemos encontrar en el suelo, plantas, alimentos, agua dulce, salada y potable (resiste la cloración). En establecimientos hospitalarios, se aísla en sistemas de agua y superficies de equipos e insumos médicos húmedos (respiradores, tubos, humidificadores y otros).
Por otra parte, en su microbiología, se describe que in vitro, su colonia es circular, lisa, mucosa, 1-2 mm de diámetro, de olor «dulzón» (figura 1). Produce un pigmento amarillo insoluble en agua (flexirubin), que expuesto a KOH al 10% se torna a naranja. Además, se expone bien en agar sangre y no se desarrolla en McConkey. En cuanto a las pruebas metabólicas positivas tenemos: indol, triptófano, esculina, gelatina, maltosa, almidón, trehalosa y citrato; negativas: hidrólisis de urea y DNAsa; resistencia a penicilina y polimixina. También se puede efectuar la identificación usando galerías y sistemas automatizados5.
También para mencionar la epsilometría (prueba para saber si una cepa especifica de una bacteria o un hongo es susceptible a la acción de antibióticos específicos) por sí sola no es aplicable a piperacilina por emitir resultados contradictorios.
Es relevante comentar que C. indologenes produce una metalobetalactamasa que proporciona resistencia a carbapenémicos. Según el estudio SENTRY[4], a nivel local, los antimicrobianos más efectivos son: levofloxacina, cotrimoxazol y piperacilina/tazobactam (> 90% de susceptibilidad). Mientras que la ciprofloxacina, cefepima y la ceftazidima muestran una actividad cercana al 85%. Los aminoglucósidos, otros (β-lactámicos, cloranfenicol, linezolid y glicopéptidos), no son considerados como efectivos.
El Chryseobacterium indologenes es un patógeno que prefiere a los pacientes inmunodeprimidos. También debido a su resistencia a la cloración puede desarrollarse en agua purificada, en las superficies dentro de los hospitales y en los dispositivos de apoyo de oxigenación y ventilación mecánica. El género Chryseobacterium incluye 6 especies que fueron previamente designadas como miembros de la familia Flavobacterium. En este grupo C indologenes y C meningosepticum son las especies con mayor repercusión clínica; sin embargo, diversos reportes demuestran que C meningosepticum es la más virulenta y afecta gravemente a niños y neonatos. El primer caso de bacteriemia en seres humanos por C indologenes fue en 1996, un análisis de 13 casos identificados en 3 años. Después de éste se han reportado pocos casos alrededor del mundo, y hasta el momento Taiwán es el área geográfica más afectada. En contraparte, en Estados Unidos, hasta el año 2013 sólo se habían reportado 7 casos, incluido uno de infección oftálmica multirresistente al tratamiento5.
El C. meningosepticum es el subtipo más patogénico, causando inclusive meningitis agresivas en neonatos prematuros con tasas de mortalidad elevadas cercanas al 57%6.
En el ámbito terapéutico los carbapenémicos, y los aminoglucósidos, no son efectivos para esta especie. Por otro lado, los agentes patógenos que usualmente acompañan esta especie son: acinetobacter baumannii (61% en algunas series) y pseudomona aureginosa (43%). In vitro el agente más activo contra CI es el trimetropin sulfa.
Discusión
El paciente reportado en este estudio presentó diversos factores de riesgo como: exposición prolongada a antibióticos de amplio espectro (carbapenémicos), uso de catéteres en varias ocasiones con la complicación de bacteriemia asociada a catéter, estancia hospitalaria prolongada, sepsis urinaria y estado de inmunocompromiso, dado por la edad del paciente, y su grado de enfermedad renal crónica, compartiendo varias características clínicas con la serie de casos de Taipei Veterans General Hospital3, no obstante en dicha serie de casos llama la atención que la media de la edad, fue menor que la del paciente de este reporte. El paciente del reporte de caso también se asemeja con la serie de casos reportados por Taipei Medical University7, en el cual el 10% de los casos tenían relación a bacteremia asociada a catéter.
Como hallazgo relevante y no menos importante, se comenta que el paciente del estudio cursó con coinfección por Acinetobacter baumannii, dato que en la literatura reporta que dicha bacteria es el germen más común que produce coinfección en pacientes con neumonía por (CI) en un 39,6%8.
La mayoría de las infecciones causadas por (CI) han sido reportadas en Taiwán, país que más ha aportado a la literatura médica en este tópico9.
Como se mencionó anteriormente C. indologenes tiene presencia relevante en pacientes con estado de inmunocompromiso, en especial en condiciones neoplásicas como tumores sólidos10. También se indica el primer caso reportado en México por sepsis grave secundaria a bacteriemia por Chryseobacterium indologenes11, se describe la infección en pacientes pediátricos12 y en pacientes oncológicos inmunocomprometidos con leucemia13, se recalca el interés por realizar el segundo reporte de caso mundial en pacientes con hemodiálisis, debido a la escasez de publicaciones en este tema, solo se cuenta con un reporte de caso en el mundo y fue en Brasil14, igualmente hay reportes aislados de pneumonia por CI y de infección urinaria por este germen15,16, todos ellos encontrados y reportados aisladamente.
Por otra parte, el estudio SENTRY (Antimicrobial Surveillance Program) demostró que las quinolonas de segunda y tercera generación, incluidas levofloxacina (100% susceptible) y ciprofloxacina (85% susceptibilidad), son los antibióticos, junto con el trimetoprim sulfa, con mayor potencia para eliminar esta bacteria. La piperacilinatazobactam, ceftazidima y cefepima reportan una susceptibilidad de 85%4.
Finalmente se reporta un caso de sepsis severa debido a Chryseobacterium indologenes en un viajero de aventura inmunocompetente y de un infante con infección por (CI) del sistema nervioso central17,18.
Conclusiones
El Chryseobacterium indologenes es una bacteria que cada día cobrará más relevancia en la medida que se usen antibióticos de mayor espectro para infecciones preexistentes por otros gérmenes multirresistentes.
Hay nuevas alternativas con antibióticos no convencionales como el cantharis19, que se podrían proponer antes del uso de antibióticos de amplio espectro, para reducir la infección bacteriana de multirresistencia.
Referencias
1. Lukowshy LR, Kheifets L, Arah OA, Nissenson AR, kalantar-Zadeh, K. Patterns and predictors of early mortality in incident hemodialysis patients: nee insights. Am J Nephrol. 2012;35:548-558. https://doi.org/10.1159/000338673.
2. Labeau SO, Vandijck Dm, Rello J, Adams S, Rosa A, Wenisch C, et al. EVIDENCE study investigator. Center for Disease control and prevention guidelines for preventing central venous catheter- related infection: results of a knowledge test among 3405 European intensive care nurses. Critic care med. 2009;37(1):320-323. https://doi.org/10.1097/CCM.0b013e3181926489.
3. Yi-Tsung Lin, Yuan-Yu Jeng, Mei-Lin Lin, Kwok-Woon Yu, Fu-Der Wang, Cheng-Yi Liu. Clinical and Microbiological Characteristics of Chryseobacterium indologenes Bacteremia. J Microbiol Immunol Infect. 2010;43(6):498-505. https://doi.org/10.1016/S1684-1182(10)60077-1.
4. Jeffrey T. Kirby, Helio S. Sader, Timothy R. Walsh, and Ronald N. Jones Antimicrobial Susceptibility and Epidemiology of a Worldwide Collection of Chryseobacterium spp.: Report from the SENTRY Antimicrobial Surveillance program (1997-2001). J Clin Microbiol. 42(1):445-448. https://doi.org/10.1128/JCM.42.1.445-448.2004.
5. Andrea Sakurada. Hospital Clínico Universidad de Chile y Complejo Asistencial Dr. Sótero del Río. Rev Chil Infect. 2008;25(6):446. http://dx.doi.org/10.4067/S0716-10182008000600005.
6. Bloch KC, Nadarajah R, Jacobs R. Chryseobacterium meningosepticum: an emerging pathogen among immunocompromised adults. Report of 6 cases and literature review. Medicine (Baltimore). 1997;76(1):30-41. http://dx.doi.org/10.1097/00005792-199701000-00003.
7. Chou DW, Wu SL, Lee CT, Tai FT, Yu WL. Clinical characteristics, antimicrobial susceptibilities, and outcomes of patients with Chryseobacterium indologenes bacteremia in an intensive care unit. Jpn J Infect Dis. 2011;64(6):520-4.
8. Chen FL, Wang GCh, Teng SO, Ou TY, Yu FL, Lee WS. Clinical and epidemiological features of Chryseobacterium indologenes infections: Analysis of 215 cases. J Microbiol Immunol Infect. 2013;46(6):425a432. http://dx.doi.org/10.1016/j.jmii.2012.08.007.
9. Hsueh PR, Teng LJ, Yang PC, Ho SW, Hsieh WC, Luh KT. Increasing incidence of nosocomial Chryseobacterium indologenes infections in Taiwan. Eur J Clin Microbiol Infect Dis. 1997;16:568-74. http://dx.doi.org/10.1007/bf02447918.
10. Christakis GB, Perlorentzou SP, Chalkiopoulou I, Athanasiou A, Legakis NJ. Chryseobacterium indologenes non-catheter-related bacteremia in a patient with a solid tumor. J Clin Microbiol. 2005;43(4):2021-3. http://dx.doi.org/10.1128/JCM.43.4.2021-2023.2005.
11. Carrillo-Esper R, Peña-Pérez CA, Neri-Maldonado R, Flores-Rivera OI, Torre-León T, et al. Sepsis grave secundaria a bacteriemia por Chryseobacterium indologenes. Primer caso reportado en México. Med Int Méx. 2015; 31:633-36.
12. Aykac K, Ozsurekc Y, Tuncer S, Ensign B, Cengiz UE, Negro A, et al. Seis casos durante 2012-2015 y revisión de la literatura de las infecciones Chryseobacterium indologenes en pacientes pediátricos. Can J Microbiol. 2016;62(10):812-819.
13. Deng L, Li MF; Li YH, Yang JL, Zhou X. Chryseobacterium indologenes en cuatro pacientes con leucemia. Transpl Infect Dis. 2015;17(4):583-7. https://doi.org/10.1111/tid.12400.
14. Gauna TT, Oshiro E, Luzio YC, Miranda PA, Jardim CE, Rodrigues MC. Bloodstream infection in patients with end-stage renal disease in a teaching hospital in central-western Brazil. Rev. Soc. Bras. Med. Trop. 46(4):426-432. http://dx.doi.org/10.1590/0037-8682-0060-2013.
15. González-Castro A, Alsasua A, Peñasco Y, Rodríguez JC, Duerto J. Tracheo-bronchitis and pneumonia associated with mechanical ventilation by Chryseobacterium indologenes. Rev Esp Anestesiol Reanim. Rev Esp Anestesiol Reanim. 2017;64(5):294-298. http://dx.doi.org/10.1016/j.redar.2016.11.011.
16. Bhuyar G, Jain S, Shah H, Mehta VK. Urinary tract infection by Chryseobacterium indologenes. Case report. Indian J Med Microbiol. 2012;30(3):370-2. http://dx.doi.org/10.4103/0255-0857.99511.
17. McKew G. Sepsis Due to Chryseobacterium indologenes in an Immunocompetent Adventure Traveler. J Clin Microbiol. 2014;52(11):4100-1. http://dx.doi.org/10.1128/JCM.01691-14.
18. Olbrich P, Rivero-Garvía M, Falcón-Neyra MD, Lepe JA, Cisneros JM, Marquez-Rivas J, Neth O. Chryseobacterium indologenes infección del sistema nervioso central en la infancia: un patógeno emergente?, Infection. 2014;42(1):179-83.
19. Reyes A, Ramirez Marmolejo R. Nuevas alternativas para el tratamiento de infección urinaria no complicada, presentación de 2 casos clínicos. Rev. Colomb. Nefrol. 2018;5(1):61-67. https://doi.org/10.22265/acnef.5.2.275.
Notas
Notas de autor
*Correspondencia: Roberto Ramírez Marmolejo, robertoramire5@hotmail.com